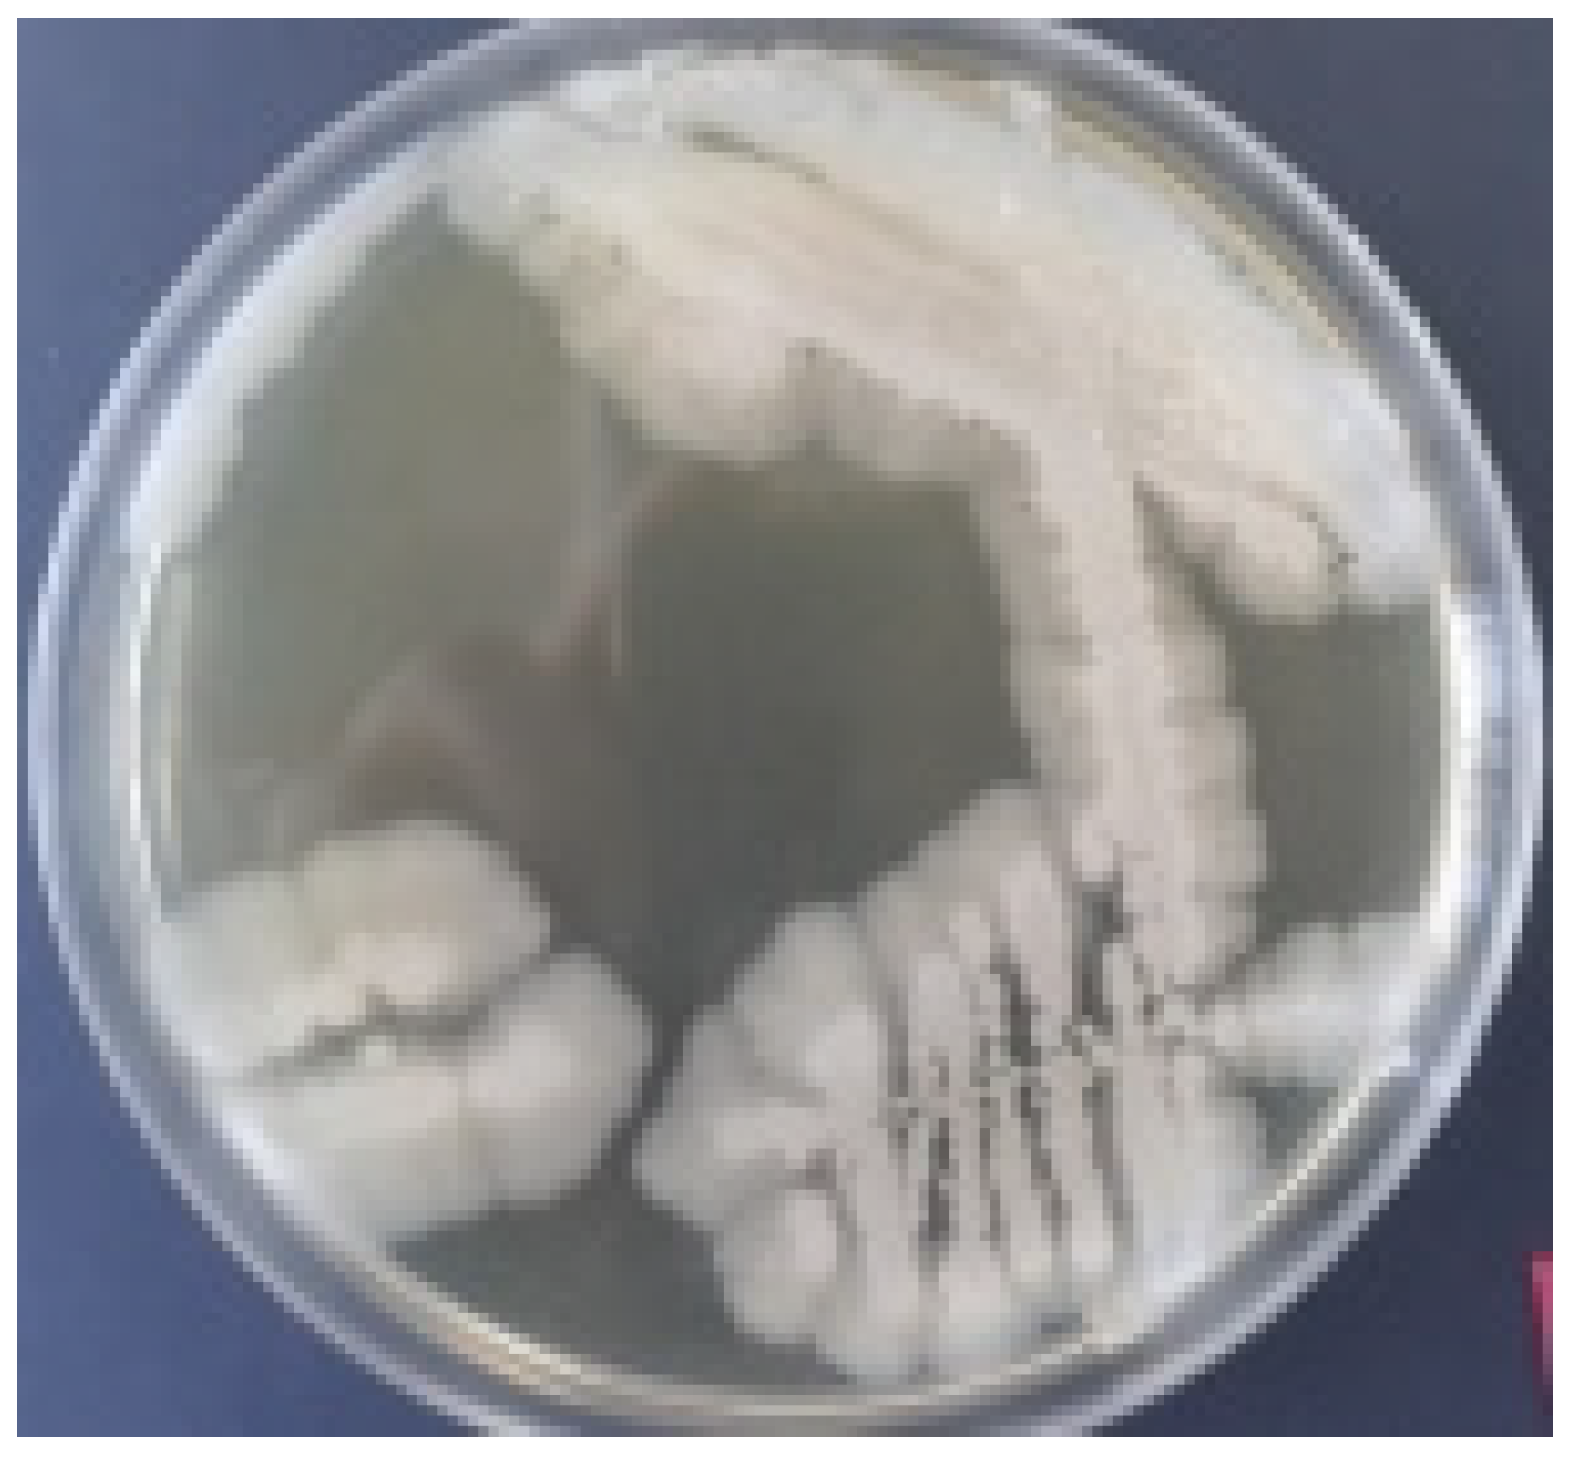
Water 14 00607 g003 Water 14 00607 g003

Nutrients Removal from Aquaculture Wastewater by Biofilter/Antibiotic-Resistant Bacteria Systems
Abstract
1. Introduction
2. Materials and Methods
2.1. Bacterial Strains
2.2. Taxonomic Identification
2.3. Antibiotic Resistance Assays
2.4. Biofilm Formation
2.5. Evaluation of Bacterial Efficiency for the Reduction of Pollutants
2.6. Statistical Analysis
3. Results and Discussion
3.1. Isolation and Identification of Bacterial Species
3.2. Bacterial Development in LB Medium
3.2.1. The Effect of Antibiotics on Bacterial Growth
3.2.2. Biofilm Formation and Retention Capacity Evaluation
- −
- Polypropylene (Figure 7a)—the peaks at 2830, 2915, and 2952 cm−1 are due to symmetric and asymmetric stretching vibrations of —CH2— and asymmetric stretching of CH3; the peaks at 1449 cm−1 and 1372 cm−1 are due to CH3 symmetric bending vibration; 994 and 971 cm−1 are due to CH3 rocking vibrations [39,40];
- −
- Polyethylene (Figure 7b)—the peaks at 2830 and 2915 cm−1 are due to symmetric and asymmetric stretching vibrations of —CH2—, 1468 cm−1 due to —CH2—bending deformation, and 718 cm−1 due to CH rocking deformation [41,42]. The low absorption (for F3 and F4) or the absence of the absorption (for F5) at 1373 cm−1 (due to methyl CH3 vibration groups) is a clear indication that the filter materials are based on high density polyethylene (HDPE). The FTIR bands at about 670, 1000 cm−1 (for F3 and F4) could be assigned to the presence of chlorine in the material structure, and the band a 3310 cm−1 (for F5) is assigned to bonded OH due to material ageing [43].
3.2.3. Optical Density Measurements
3.3. Bacteria Development in Synthetic Medium
3.3.1. The Effect of Antibiotics on Bacterial Growth
3.3.2. Biofilm Formation and Retention Capacity Evaluation
3.4. Strain Efficiency and Nutrient Content Removal in Aquaculture Wastewaters
4. Conclusions
Author Contributions
Funding
Institutional Review Board Statement
Informed Consent Statement
Data Availability Statement
Conflicts of Interest
References
- OECD. Aquaculture Production (Indicator); OECD Publishing: Paris, France, 2021. [Google Scholar] [CrossRef]
- Zhang, K.; Yu, D.; Li, Z.; Xie, J.; Wang, G.; Gong, W.; Yu, E.; Tian, J. Influence of eco-substrate addition on organic carbon, nitrogen and phosphorus budgets of intensive aquaculture ponds of the Pearl River, China. Aquaculture 2020, 520, 734868. [Google Scholar] [CrossRef]
- John, E.M.; Krishnapriya, K.; Sankar, T.V. Treatment of ammonia and nitrite in aquaculture wastewater by an assembled bacterial consortium. Aquaculture 2020, 526, 735390. [Google Scholar] [CrossRef]
- Islam, M.; Yasmin, R. Impact of Aquaculture and Contemporary environmental issues in Bangladesh. Int. J. Fish. Aquat. Stud. 2017, 5, 100–107. [Google Scholar]
- Pérez-Sánchez, T.; Mora-Sánchez, B.; Balcázar, J.L. Biological Approaches for Disease Control in Aquaculture: Advantages, Limitations and Challenges. Trends. Microbiol. 2018, 26, 896–903. [Google Scholar] [CrossRef]
- Choi, S.; Sim, W.; Jang, D.; Yoon, Y.; Ryu, J.; Oh, J.; Woo, J.S.; Kim, Y.M.; Lee, Y. Antibiotics in coastal aquaculture waters: Occurrence and elimination efficiency in oxidative water treatment processes. J. Hazard. Mater. 2020, 396, 122585. [Google Scholar] [CrossRef]
- Moe, S.J.; Hjermann, D.Ø.; Ravagnan, E.; Bechmann, R.K. Effects of an aquaculture pesticide (diflubenzuron) on non-target shrimp populations: Extrapolation from laboratory experiments to the risk of population decline. Ecol. Model. 2019, 413, 108833. [Google Scholar] [CrossRef]
- OECD. Agriculture’s Impact on Aquaculture: Hypoxia and Eutrophication in Marine Waters; OECD Publishing: Paris, France, 2012. [Google Scholar]
- Lozano Avilés, A.B.; Del Cerro Velázquez, F.; Llorens Pascual Del Riquelme, M. Methodology for Energy Optimization in Wastewater Treatment Plants. Phase I: Control of the Best Operating Conditions. Sustainability 2019, 11, 3919. [Google Scholar] [CrossRef]
- Beckinghausen, A.; Odlare, M.; Thorin, E.; Schwede, S. From removal to recovery: An evaluation of nitrogen recovery techniques from wastewater. Appl. Energy 2020, 263, 114616. [Google Scholar] [CrossRef]
- Bilotta, G.S.; Brazier, R.E. Understanding the influence of suspended solids on water quality and aquatic biota. Water Res. 2008, 42, 2849–2861. [Google Scholar] [CrossRef]
- Cripps, S.J.; Bergheim, A. Solids management and removal for intensive land-based aquaculture production systems. Aquacult. Eng. 2000, 22, 33–56. [Google Scholar] [CrossRef]
- Capodaglio, A.; Olsson, G. Energy Issues in Sustainable Urban Wastewater Management: Use, Demand Reduction and Recovery in the Urban Water Cycle. Sustainability 2019, 12, 266. [Google Scholar] [CrossRef]
- Lananan, F.; Abdul Hamid, S.H.; Din, W.N.S.; Ali, N.A.; Khatoon, H.; Jusoh, A.; Endut, A. Symbiotic bioremediation of aquaculture wastewater in reducing ammonia and phosphorus utilizing Effective Microorganism (EM-1) and microalgae (Chlorella sp.). Int. Biodeterior. Biodegrad. 2014, 95, 127–134. [Google Scholar] [CrossRef]
- Chen, Y.; Zhang, C.; Li, Y. Ultrasonic-assisted Biodegradation of Endocrine Disrupting Compounds in Soil by Pseudomonas putida: The Importance of Rhamnolipid for Intermediate Product Degradation. Chem. Res. Chin. Univ. 2017, 33, 179–186. [Google Scholar] [CrossRef]
- Kanaujiya, D.K.; Paul, T.; Sinharoy, A.; Pakshirajan, K. Biological Treatment Processes for the Removal of Organic Micropollutants from Wastewater: A Review. Curr. Pollut. Rep. 2019, 5, 112–128. [Google Scholar] [CrossRef]
- Jin, X.; Zhao, Z.; Qin, Z.; Lu, D.; Liang, S.-X. Distribution and degradation of organic matter with different molecular weight in an A2/O treatment system. Appl. Water Sci. 2017, 7, 3497–3502. [Google Scholar] [CrossRef][Green Version]
- Gutierrez-Wing, M.T.; Malone, R.F. Biological filters in aquaculture: Trends and research directions for freshwater and marine applications. Aquacult. Eng. 2006, 34, 163–171. [Google Scholar] [CrossRef]
- Schar, D.; Klein, E.Y.; Laxminarayan, R.; Gilbert, M.; Van Boeckel, T.P. Global trends in antimicrobial use in aquaculture. Sci. Rep. 2020, 10, 21878. [Google Scholar] [CrossRef]
- Çetecioglu, Z.; Atasoy, M. Biodegradation and inhibitory effects of antibiotics on biological wastewater treatment systems. In Toxicity and Biodegradation Testing, Methods in Pharmacology and Toxicology; Bidola, E., Montagnolli, R., Eds.; Humana Press: New York, NY, USA, 2018; pp. 29–55. [Google Scholar]
- Hassan, M.; Zhu, G.; Lu, Y.-z.; Al-Falahi, A.H.; Lu, Y.; Huang, S.; Wan, Z. Removal of antibiotics from wastewater and its problematic effects on microbial communities by bioelectrochemical Technology: Current knowledge and future perspectives. Environ. Eng. Res. 2021, 26, 190400–190405. [Google Scholar] [CrossRef]
- Romero, J.; Gloria, C.; Navarrete, P. Antibiotics in Aquaculture—Use, Abuse and Alternatives. In Health and Environment in Aquaculture; Carvalho, E., Ed.; BoD—Books on Demand: Norderstedt, Germany, 2012; pp. 159–198. [Google Scholar]
- Libretex. API20E Multitest Strip. Available online: https://bio.libretexts.org/Demos%2C_Techniques%2C_and_Experiments/Microbiology_Labs_I/43%3A_API-20E_multitest_strip (accessed on 25 January 2022).
- Cowgill, U.M.; Milazzo, D.P. The Culturing and Testing of Two Species of Duckweed; Cowgill, U.M., Williams, L.R., Eds.; ASTM International: West Conshohocken, PA, USA, 1989; pp. 379–391. [Google Scholar]
- Cataldo, D.A.; Maroon, M.; Schrader, L.E.; Youngs, V.L. Rapid colorimetric determination of nitrate in plant tissue by nitration of salicylic acid. Commun. Soil. Sci. Plant Anal. 1975, 6, 71–80. [Google Scholar] [CrossRef]
- Porche, M. Spectrophotometric Determination of Nitrite by Derivatization with Captopril. Master’s Thesis, Miami University, Oxford, OH, USA, 2014. Available online: http://rave.ohiolink.edu/etdc/view?acc_num=miami1399075201 (accessed on 25 January 2022).
- Koroleff, F. Determination of ammonia. In Methods of Seawater Analysis; Wiley-VCH: Weinheim, Germany, 1983. [Google Scholar]
- Fiske, C.H.; Subbarow, Y. The colorimetric determination of phosphorus. J. Biol. Chem. 1925, 66, 375–400. [Google Scholar] [CrossRef]
- Pascale, G.; Popescu, R.; Stancu, C.; Nica, E.; Gabor, V.D.; Crăciun, N.; Stoian, G. Adaptative Responses of Two Fabaceae Species to Heavy Crude Oil of Polluted and Remediated Soils. Int. J. Agric. Innov. Res. 2016, 5, 142–148. [Google Scholar]
- Brodsky, M.H.; Nixon, M.C. Rapid Method for Detection of Pseudomonas aeruginosa on MacConkey Agar under Ultraviolet Light. Appl. Microbiol. 1973, 26, 219–220. [Google Scholar] [CrossRef]
- An, Q.; Deng, S.; Xu, J.; Nan, H.; Li, Z.; Song, J.-L. Simultaneous reduction of nitrate and Cr(VI) by Pseudomonas aeruginosa strain G12 in wastewater. Ecotoxicol. Environ. Saf. 2020, 191, 110001. [Google Scholar] [CrossRef] [PubMed]
- Kamika, I.; Momba, M.N.B. Assessing the resistance and bioremediation ability of selected bacterial and protozoan species to heavy metals in metal-rich industrial wastewater. BMC Microbiol. 2013, 13, 28. [Google Scholar] [CrossRef]
- Thi, M.T.T.; Wibowo, D.; Rehm, B.H.A. Pseudomonas aeruginosa Biofilms. Int. J. Mol. Sci. 2020, 21, 8671. [Google Scholar] [CrossRef]
- Delgado, M.C.G.; Garcia-Mayorgas, A.D.; Rodriguez, F.; Ibarra, A.; Casal, M. Susceptibility and resistence of Pseudomonas aeruginosa to antimicrobial agents. Rev. Esp. Quimioter. 2007, 20, 230–233. [Google Scholar]
- Verma, K.; Saha, G.; Kundu, L.M.; Dubey, V.K. Biochemical characterization of a stable azoreductase enzyme from Chromobacterium violaceum: Application in industrial effluent dye degradation. Int. J. Biol. Macromol. 2019, 121, 1011–1018. [Google Scholar] [CrossRef]
- Faramarzi, M.A.; Stagars, M.; Pensini, E.; Krebs, W.; Brandl, H. Metal solubilization from metal-containing solid materials by cyanogenic Chromobacterium violaceum. J. Biotechnol. 2004, 113, 321–326. [Google Scholar] [CrossRef] [PubMed]
- Zhu, K.; Chen, S.; Sysoeva, T.A.; You, L. Universal antibiotic tolerance arising from antibiotic-triggered accumulation of pyocyanin in Pseudomonas aeruginosa. PLoS Biol. 2019, 17, e3000573. [Google Scholar] [CrossRef] [PubMed]
- Rahman, M.R.; Lou, Z.; Zhang, J.; Yu, F.; Timilsena, Y.P.; Zhang, C.; Zhang, Y.; Bakry, A.M. Star Anise (Illicium verum Hook. f.) as Quorum Sensing and Biofilm Formation Inhibitor on Foodborne Bacteria: Study in Milk. J. Food Prot. 2017, 80, 645–653. [Google Scholar] [CrossRef] [PubMed]
- Fang, J.; Zhang, L.; Sutton, D.; Wang, X.G.; Lin, T. Needleless Melt-Electrospinning of Polypropylene Nanofibres. J. Nanomater. 2012, 2012, 382639. [Google Scholar] [CrossRef]
- Lungulescu, M.E.; Zaharescu, T.; Plesa, I.; Podina, C. Thermal and radiation stability of polyolefins modified with silica nanoparticles. J. Optoelectron. Adv. Mater. 2014, 16, 719–725. [Google Scholar]
- Lungulescu, E.-M. Contributions to the Study and Characterization of Degradation Processes of the Insulating Polymeric Materials in High-Energy Radiation Fields. Ph.D. Thesis, University of Bucharest, Bucharest, Romania, 2014. [Google Scholar]
- Gulmine, J.V.; Janissek, P.R.; Heise, H.M.; Akcelrud, L. Polyethylene characterization by FTIR. Polym. Test. 2002, 21, 557–563. [Google Scholar] [CrossRef]
- Ilie, S.; Setnescu, R.; Lungulescu, E.M.; Marinescu, V.; Ilie, D.; Setnescu, T.; Mares, G. Investigations of a mechanically failed cable insulation used in indoor conditions. Polym. Test. 2011, 30, 173–182. [Google Scholar] [CrossRef]
- Garrett, T.R.; Bhakoo, M.; Zhang, Z. Bacterial adhesion and biofilms on surfaces. Prog. Nat. Sci. 2008, 18, 1049–1056. [Google Scholar] [CrossRef]
- Ghafoor, A.; Hay, I.D.; Rehm, B.H. Role of exopolysaccharides in Pseudomonas aeruginosa biofilm formation and architecture. Appl. Environ. Microbiol. 2011, 77, 5238–5246. [Google Scholar] [CrossRef] [PubMed]
- Becker, S.; Soares, C.; Porto, L.M. Computational analysis suggests that virulence of Chromobacterium violaceum might be linked to biofilm formation and poly-NAG biosynthesis. Genet. Mol. Biol. 2009, 32, 640–644. [Google Scholar] [CrossRef] [PubMed]
- Carson, M.C.; Bullock, G.; Bebak-Williams, J. Determination of oxytetracycline residues in matrixes from a freshwater recirculating aquaculture system. J. AOAC Int. 2002, 85, 341–348. [Google Scholar] [CrossRef] [PubMed]
- Schreier, H.J.; Mirzoyan, N.; Saito, K. Microbial diversity of biological filters in recirculating aquaculture systems. Curr. Opin. Biotechnol. 2010, 21, 318–325. [Google Scholar] [CrossRef]
- Vanysacker, L.; Denis, C.; Declerck, P.; Piasecka, A.; Vankelecom, I.F. Microbial adhesion and biofilm formation on microfiltration membranes: A detailed characterization using model organisms with increasing complexity. Biomed. Res. Int. 2013, 2013, 470867. [Google Scholar] [CrossRef]
- Baquero, F.; Martínez, J.-L.; Cantón, R. Antibiotics and antibiotic resistance in water environments. Curr. Opin. Biotechnol. 2008, 19, 260–265. [Google Scholar] [CrossRef] [PubMed]
- Cydzik-Kwiatkowska, A.; Wojnowska-Baryla, I. Nitrogen-converting communities in aerobic granules at different hydraulic retention times (HRTs) and operational modes. World J. Microbiol. Biotechnol. 2015, 31, 75–83. [Google Scholar] [CrossRef] [PubMed]
- Peng, X.; Guo, F.; Ju, F.; Zhang, T. Shifts in the microbial community, nitrifiers and denitrifiers in the biofilm in a full-scale rotating biological contactor. Environ. Sci. Technol. 2014, 48, 8044–8052. [Google Scholar] [CrossRef] [PubMed]
- Schneider, O.; Sereti, V.; Eding, E.H.; Verreth, J.A.J. Analysis of nutrient flows in integrated intensive aquaculture systems. Aquacult. Eng. 2005, 32, 379–401. [Google Scholar] [CrossRef]

| Code | F1 | F2 | F3 | F4 | F5 | F6 |
|---|---|---|---|---|---|---|
| Diameter/Height (mm) | 15/11 | 15/9.3 | 15/8.8 | 15/10.5 | 17/17.9 | 14.8/14.5 |
| Structure |  |  |  |  |  |  |
| Chemical nature * | PP | PP | PE | PE | PE | PP |
| Ions | Initial Concentration (µg/mL) | Wavenumber (nm) | References |
|---|---|---|---|
| NO3−-N | 162.76 | 410 | [25] |
| NO2−-N | 647.3 | 333 | [26] |
| NH4+-N | 132.0 | 630 | [27] |
| PO43− | 4.69 | 660 | [28] |
| Strain | OTC (µg/mL) | Biofilm Mass (mg) | |||||
|---|---|---|---|---|---|---|---|
| F1 | F2 | F3 | F4 | F5 | F6 | ||
| P. aeruginosa * | 0 | 20.9 ± 1.8 | 19.5 ± 2.1 | 30.9 ± 3.2 | 34.2 ± 2.4 | 55.8 ± 5.2 | 49.6 ± 3.4 |
| 0.1 | 14.6 ± 1.3 | 14.2 ± 2.0 | 18.4 ± 2.5 | 20.1 ± 1.5 | 33.5 ± 2.1 | 28.3 ± 2.4 | |
| 0.2 | 10.1 ± 1.6 | 13.7 ± 1.0 | 15.4 ± 1.7 | 18.1 ± 1.4 | 32.4 ± 1.9 | 29.4 ± 2.0 | |
| 0.4 | 4.6 ± 0.8 | 6.2 ± 0.6 | 10.9 ± 1.2 | 11.8 ± 0.9 | 10.4 ± 1.0 | 3.6 ± 0.5 | |
| C. violaceum * | 0 | 38.3 ± 2.5 | 25.6 ± 1.9 | 21.6 ± 2.1 | 56.9 ± 4.8 | 80.6 ± 6.8 | 65.6 ± 3.6 |
| 0.1 | 20.2 ± 2.0 | 16.0 ± 1.4 | 9.9 ± 1.0 | 30.2 ± 2.0 | 52.9 ± 4.6 | 46.3 ± 3.2 | |
| 0.2 | 18.6 ± 1.9 | 15.2 ± 1.2 | 13.6 ± 1.3 | 19.6 ± 0.9 | 40.2 ± 2.4 | 34.5 ± 2.9 | |
| 0.4 | 17.2 ± 2.0 | 11.0 ± 1.4 | 8.4 ± 1.2 | 5.6 ± 0.6 | 6.6 ± 0.9 | 12.8 ± 0.8 | |
| Strain | OTC (µg/mL) | Biofilm Mass (mg) | |||||
|---|---|---|---|---|---|---|---|
| F1 | F2 | F3 | F4 | F5 | F6 | ||
| P. aeruginosa * | 0 | 142.1 ± 15.3 | 210.6 ± 11.4 | 160.2 ± 10.3 | 286.3 ± 15.4 | 450.0 ± 32.5 | 305.9 ± 21.4 |
| C. violaceum * | 0 | 193.2 ± 13.6 | 280.8 ± 21.2 | 199.9 ± 19.2 | 215.2 ± 18.7 | 492.9 ± 25.6 | 400.5 ± 38.2 |
| P.aeruginosa * | 0.2 | 131.5 ± 12.7 | 201.6 ± 10.3 | 153.7 ± 14.9 | 261.7 ± 19.3 | 438.8 ± 26.1 | 283.7 ± 20.7 |
| C. violaceum * | 0.2 | 189.1 ± 15.3 | 266.3 ± 21.4 | 196.6 ± 20.9 | 199.5 ± 14.8 | 471.9 ± 24.5 | 388.4 ± 31.0 |
| Strain | Ions | Removal Efficiency (%) | |||||
|---|---|---|---|---|---|---|---|
| F1 | F2 | F3 | F4 | F5 | F6 | ||
| P. aeruginosa | NO3−-N | 86.1 | 76.4 | 85.1 | 84.9 | 84.9 | 85.4 |
| NO2−-N | 87.0 | 84.5 | 83.7 | 85.5 | 78.8 | 83.1 | |
| NH4+ | 1.4 | 0.2 | 1.4 | 2.1 | 0.7 | 9.9 | |
| PO43− | 28.8 | 24.1 | 56.1 | 18.3 | 62.0 | 16.2 | |
| C. violaceum | NO3−-N | 84.1 | 84.0 | 85.0 | 85.1 | 85.1 | 85.2 |
| NO2−-N | 81.7 | 76.4 | 82.8 | 90.2 | 78.8 | 83.4 | |
| NH4+ | 1.1 | 1.1 | 1.1 | 1.1 | 10.1 | 1.1 | |
| PO43− | 36.9 | 26.4 | 61.6 | 22.2 | 42.2 | 17.3 | |
Publisher’s Note: MDPI stays neutral with regard to jurisdictional claims in published maps and institutional affiliations. |
© 2022 by the authors. Licensee MDPI, Basel, Switzerland. This article is an open access article distributed under the terms and conditions of the Creative Commons Attribution (CC BY) license (https://creativecommons.org/licenses/by/4.0/).
Share and Cite
Nicula, N.-O.; Lungulescu, E.-M.; Ieropoulos, I.A.; Rimbu, G.A.; Csutak, O. Nutrients Removal from Aquaculture Wastewater by Biofilter/Antibiotic-Resistant Bacteria Systems. Water 2022, 14, 607. https://doi.org/10.3390/w14040607
Nicula N-O, Lungulescu E-M, Ieropoulos IA, Rimbu GA, Csutak O. Nutrients Removal from Aquaculture Wastewater by Biofilter/Antibiotic-Resistant Bacteria Systems. Water. 2022; 14(4):607. https://doi.org/10.3390/w14040607
Chicago/Turabian StyleNicula, Nicoleta-Oana, Eduard-Marius Lungulescu, Ioannis A. Ieropoulos, Gimi A. Rimbu, and Ortansa Csutak. 2022. "Nutrients Removal from Aquaculture Wastewater by Biofilter/Antibiotic-Resistant Bacteria Systems" Water 14, no. 4: 607. https://doi.org/10.3390/w14040607
APA StyleNicula, N.-O., Lungulescu, E.-M., Ieropoulos, I. A., Rimbu, G. A., & Csutak, O. (2022). Nutrients Removal from Aquaculture Wastewater by Biofilter/Antibiotic-Resistant Bacteria Systems. Water, 14(4), 607. https://doi.org/10.3390/w14040607







